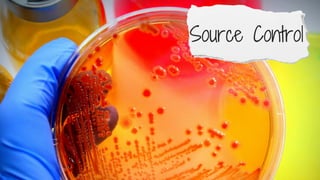
Too Sick for Surgery - Steve Mathieu

Embed presentation
Download as PDF, PPTX























This talk will cover what we should do for patients who are considered too sick to have emergency surgery. These patients provide major management challenges in Critical Care. Do we admit them to intensive care to optimise them prior to emergency surgery or should we get on with surgery and resuscitate them intraoperatively? Should the surgery, if undertaken, be limited to damgae control surgery or operative resuscitation, or should more definitive surgical procedures be undertaken. There often isn't good evidence to mandate a course of action either way so the decision will mostly be based on the treating clinicians opinions. In these complex cases, who should decide? These factors and others will be examined